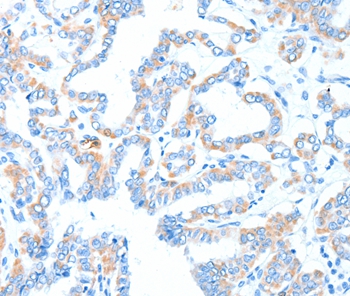

Gpt Polyclonal Antibody
CAC08496
ApplicationsImmunoFluorescence, ImmunoPrecipitation, Western Blot, ELISA, ImmunoHistoChemistry
Product group Antibodies
TargetGPT
Overview
- SupplierBiomatik
- Product NameGpt Polyclonal Antibody
- Delivery Days Customer12
- ApplicationsImmunoFluorescence, ImmunoPrecipitation, Western Blot, ELISA, ImmunoHistoChemistry
- Applications SupplierELISA, WB, IHC, IF, IP; Recommended dilution: WB:1:500-1:5000, IHC:1:200-1:500, IF:1:50-1:200, IP:1:200-1:2000
- CertificationResearch Use Only
- ClonalityPolyclonal
- ConjugateUnconjugated
- Gene ID2875
- Target nameGPT
- Target descriptionglutamic--pyruvic transaminase
- Target synonymsAAT1, ALT, ALT1, GPT1, SGPT, alanine aminotransferase 1, alanine aminotransferase, alanine transaminase, glutamate pyruvate transaminase 1, glutamic--pyruvic transaminase 1, glutamic-alanine transaminase 1, glutamic-pyruvate transaminase (alanine aminotransferase)
- HostRabbit
- IsotypeIgG
- Protein IDP24298
- Protein NameAlanine aminotransferase 1
- Scientific DescriptionThe Gpt Polyclonal Antibody (Species: Human) has been validated for the following applications: ELISA, WB, IHC, IF, IP.
- Reactivity SupplierHuman, Mouse, Rat
- Storage Instruction-20°C,2°C to 8°C
- UNSPSC12352203